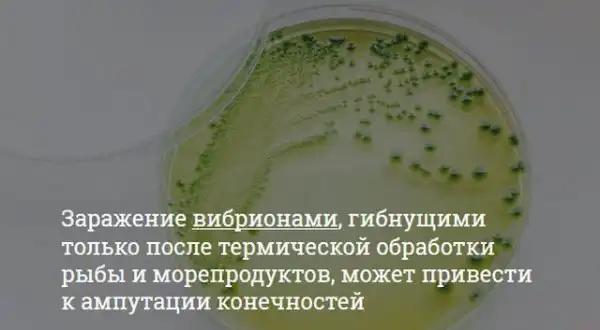

Японские блюда в последнее время стали настолько популярными, что насчитывают миллионы поклонников во всем мире. Однако не стоит забывать и о том, что японская кухня славится не только высокими вкусовыми качествами, но еще и некоторыми рисками для здоровья, с которыми вы сможете ознакомиться в продолжении поста.